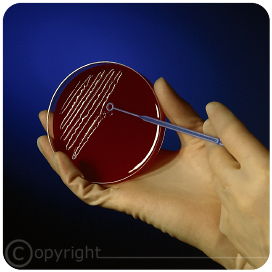
Mikrobiologie AQUENY

Wasseranalysen mikrobiologisch
Leistungsübersicht > Dienstleistungen
In Absprache mit den zuständigen Gesundheitsämtern führen wir als unabhängige, zertifizierte Probenehmer mikrobiologische Untersuchungen durch. Wir arbeiten mit akkreditierten Labors zusammen, damit die Befunde aussagekräftige Ergebnisse liefern. Strenge Qualitätsstandards werden über Ringversuche dauerhaft abgesichert. Über stetige Überprüfungen zur Arbeitsweise und den Analyseergebnissen wird auch hier die Qualität sichergestellt.
Anwendungen sind zum Beispiel:
Trinkwasser kalt
Trinkwasser war
u.a.
Sehr gern stehen wir Ihnen an dieser Stelle mit unseren Dienstleistungen zur Verfügung.
Mit Inkrafttreten der novellierten Trinkwasserverordnung im Dezember 2012 sind Großanlagen zur Trinkwassererwärmung in öffentlichen oder gewerblich genutzten Trinkwasserinstallationen mindestens alle 3 Jahre systemisch auf die Einhaltung der erlaubten Grenzwerte bzw. technischen Maßnahmewerte chemisch und mikrobiologisch, im Besonderen auf Legionellen (Legionella Species), zu überprüfen. Jeder Inhaber oder Betreiber einer öffentlich und/oder gewerblich genutzten Trinkwasserinstallation ist zu jeder Zeit für die von seiner Anlage ausgehende Wasserqualität verantwortlich. Dies betrifft sämtliche Parameter der Trinkwasserverordnung - im Kalt- und Warmwasser.
In Krankenhäusern und anderen sensiblen Einrichtungen gehen die mikrobiologischen Kontrollen und Maßnahmen weit darüber hinaus. Überall dort, wo immunsupprimierte Personen mit Trinkwasser in Kontakt kommen oder es verzehren, sind weitere Vorsichtsmaßnahmen unverzichtbar.
Deshalb sind deutlich umfangreichere und auch endständige Kontrollen an den Ausgabestellen notwendig. Sinnvollerweise möchten wir diese orientierenden und weitergehenden Untersuchungen, in Absprache, auch auf andere Verwender erweitern. Denn eines muss man einschränkend einräumen; jede noch so penibel gezogene und analysierte Probe ist jeweils nur eine Momentaufnahme.
Aber auch zahlreiche andere mikrobiologische und chemische Parameter des abgegebenen Trinkwassers in einer Hausinstallation sind in Betreiberverantwortung und daher regelmäßig zu überprüfen, sowie ggfs. Maßnahmen zur Abhilfe einzuleiten. Aus hygienischer Sicht besteht keinerlei Unterschied zwischen einer großen oder kleinen Trinkwasserinstallation. Gesundheitsschutz sollte oberste Priorität haben.
Trinkwasserinstallationen sind in ihrer Funktion zur Lagerung und Verteilung des Nahrungsmittels Trinkwasser, praktisch ständig wechselnden Einflüssen ausgesetzt. Die Errichtung und der Betrieb der Anlagen mindestens nach den anerkannten regeln der Technik und die Unterhaltung von Trinkwasserinstallationen, wie sie die DIN Normen VDI-Richtlinien und andere einschlägigen Arbeitsblätter beschreiben, sind unverzichtbar. Trinkwasser ist wie andere Lebensmittel verderblich und hat nur eine begrenzte Haltbarkeit. Das erklärt den Widerspruch von der als "SEHR GUT" bewerteten Trinkwasserqualität in Deutschland und den Berichten von "Gefahren aus dem Trinkwasser". Die Trinkwasserversorger liefern ein sehr streng kontrolliertes und qualitativ hochwertiges Lebensmittel. In der eigenen Trinkwasserinstallation und auf den langen Transportwegen kann sich die Qualität jedoch auch nachteilig verändern.
Üblicherweise benötigen mikrobiologische Untersuchen im Labor durch exakte "Bebrütung" auf den Nährlösungen genaue Zeiträume zur qualitativen und quantitativen Bestimmung der Keime in KBE. Von der Probenahme bis zum Befund benötigt man etwa 10 Tage.
Wir werden in Kürze eine sehr viel schnellere Nachweismethode anbieten können, um z.B. Legionellen und Pseudomonas Aeruginosa bestimmen zu können.
Weiter zu Wasseranalysen chemisch mehr...
